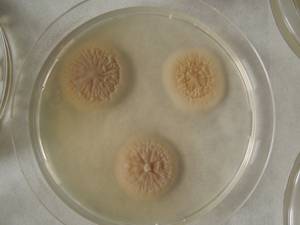
MSU_FS-02149 01, Район Тан Шон (Thanh Sơn district), Bến Tre Province (Vietnam)

Total items: 1
Total pages: 1
Organisms
- Specimen ID
- 0000000905102
- Species
- Acremonium chrysogenum
- Strain
- MSU_FS-02149
- Place of isolation
- Район Тан Шон (Thanh Sơn district), Bến Tre Province (Vietnam)
- Placename
- Суан Шон (Xuân Sơn commune)